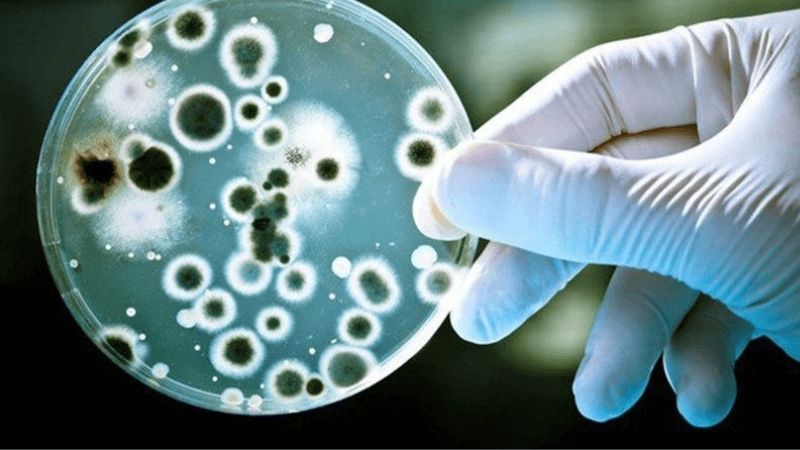

Hãy khám phá hiệu quả của cát cánh trong việc trị ho, long đờm và viêm họng. Đọc bài viết dưới đây để hiểu rõ hơn về loại dược liệu này và các lưu ý khi sử dụng.
Cây cát cánh có tác dụng khứ đàm, khai thông phế khí, bổ phế, tốt cho hầu họng. Vì thế, vị thuốc tự nhiên này thường được sử dụng điều trị viêm họng, tiểu tiện không lợi, ho có nhiều đờm và một số bệnh lý khác.
1Cát cánh là gì?
Cây cát cánh còn có tên gọi khác là Tề ni, khổ ngạch, bạch dược, cánh thảo, mộc tiện, đô ất la sất, cát tưởng xử hoặc khổ cánh (Hòa hán Dược Khảo), lư như, lợi như, phòng đồ, phù hổ và phương đồ. Tên khoa học của nó là Platycodon grandiflorum thuộc họ hoa chuông Campanulaceae.
Loài cây này có nguồn gốc từ khu vực Đông Bắc của Châu Á, phân bố chủ yếu ở Trung Quốc, Nhật Bản và Triều Tiên.
Đây là một loại cây lâu năm thường trồng ở vùng núi và cánh đồng. Cát cánh cao từ 50 đến 90 cm, có rễ dày, nhựa trắng chảy ra khi thân cây bị cắt.
Lá dài từ 3 đến 6 cm, mọc vòng hoặc đối xứng nhau, không có cuống, phiến lá hình trắng, mép lá có răng cưa to và lá trên thân mọc cách.
Hoa cát cánh có hình chuông, màu xanh lam và mép có 5 thùy, các thùy có gân nổi rõ. Hoa thường mọc vào tháng 5-8, quả hình trứng ngược vào mùa ở tháng 7 đến tháng 9 hàng năm.
Rễ củ nạc, bên ngoài có màu vàng nhạt và là bộ phận dùng làm dược liệu.
Cát cánh thu hoạch vào tháng 2 - 8 hàng năm. Sau thu hoạch, chúng được rửa sạch và sau đó đem phơi hoặc sấy khô.
Vị thuốc cát cánh có chứa nhiều thành phần hóa học như Polygalain acid, A-spinasteryl-b -D-glucoside, Platycodigenin, Betulin, Platycogenic acid, Alpha-spinasterol, Stigmasterol.

Hoa cát cánh có hình chuông, màu xanh lam và mép có 5 thùy, các thùy có gân nổi rõ
2Cát cánh có tác dụng gì?
Theo Y học cổ truyền
Cát cánh không chỉ có tác dụng bài nùng, tuyên phế khử đàm, mà còn giúp khai thông phế khí. Nhờ vào những đặc tính này, cát cánh thường được sử dụng để điều trị các vấn đề như họng đau nói khàn, chứng lụ, tiểu tiện lung bế, áp xe phổi, ho có đờm nhiều và viêm họng sưng đau. Chính vì vậy, theo Y học cổ truyền, cát cánh có những tác dụng sau:
- Chữa ngoại cảm sinh ho, cổ họng sưng đau, ngực đầy trướng đau, ho ra máu, mủ.
- Các cánh thường dùng điều trị các bệnh như khí thúc thấu nghịch, đàm diên, phá huyết, chủ trúng ác (nhiễm độc), chủ phế khí, tiêu tích tụ, trẻ em bị động kinh hoặc khử tích khí. (Theo Sách Dược Tính Bản Thảo)
- Duy kỳ thương nhập phế kinh, cổ năng sử chư khí hạ giáng, phế vị chủ khí chi tạng. (Theo Sách Bản Thảo Thông Huyền)
- Công dụng phong tý, liệu hầu yết thống, lợi ngũ tạng trường vị, hạ cổ độc (trừ độc của sâu), trừ hàn nhiệt, ông trung tiêu cốc, bổ khí huyết. (Theo Theo sách Danh Y Biệt Lục)
- Giảm đau, giải nhiệt, ức chế hệ miễn dịch, chống viêm loét dạ dày, an thần. (Theo Trung Dược học)

Cát cánh có tác dụng trị ho, long đàm, bổ phế
Theo Y học hiện đại
Cây thuốc cát cánh có vị cay tính hơi ôn, vị đắng không có độc. Theo Y học hiện đại cát cánh có những tác dụng như:
- Hệ hô hấp: long đờm và giảm ho hiệu quả vì saponin trong cát cánh có tác dụng trừ đờm mạnh do khi uống, chất này gây kích thích niêm mạc cổ họng và dạ dày đưa đến phản xạ tăng phân tiết ở đường hô hấp làm cho đờm loãng ra và dễ tống ra ngoài.
- Ảnh hưởng nội tiết: nước được sắc từ dược liệu cát cánh có khả năng làm giảm đường huyết của thỏ, đặc biệt là đối với những con thỏ được gây tiểu đường nhân tạo.
- Chuyển hóa Lipid: dùng nước sắc từ cát cánh cho chuột uống, kết quả cho thấy giúp làm giảm cholesterol trong gan và đồng thời thúc đẩy chuyển hóa cholesterol trong cơ thể.
- Kháng nấm: nước sắc từ cây cát cánh có thể gây ức chế được hầu hết các loại nấm gây bệnh trên da.
- Huyết học: thành phần saponin trong cát cánh có tác dụng giúp tán huyết mạnh. Tuy nhiên, thành phần này thường bị phân hủy khi sử dụng qua đường uống.
Nước sắc từ cây cát cánh có thể gây ức chế được hầu hết các loại nấm gây bệnh trên da
3Liều dùng Cát cánh
Bạn có thể nấu bằng siêu sắc thuốc. Liều dùng tối đa là 4 - 12 gram mỗi ngày, tuy nhiên, nên tuân thủ hướng dẫn của bác sĩ hoặc nhà sản xuất.

Thường được sử dụng dưới dạng nước sắc và liều lượng tối đa là từ 4 đến 12 gram mỗi ngày
4Một số bài thuốc có sử dụng cát cánh
Bài thuốc cát cánh cam thảo thang chữa ho tiêu đờm
Hỗn hợp dược liệu này bao gồm 4g cát cánh, 8g cam thảo, pha trong 600ml nước và lọc còn lại 200ml. Uống 3 lần mỗi ngày có thể giúp chữa ho và tiêu đờm. Đây là đơn thuốc được Trường Trọng Cảnh khuyến nghị.

Thang thuốc cát cánh cam thảo giúp chữa ho và tiêu đờm
Bài thuốc chữa cam răng, miệng hôi
Bạn có thể tận dụng cát cánh và hồi hương, tán nhỏ và trộn đều để bôi lên vùng cam răng sau khi đã rửa sạch. Điều này có thể giúp làm sạch và cung cấp dưỡng chất cho nướu và răng.
Bài thuốc cát cánh hoàn chữa mắt đau do can phong thịnh
Để chuẩn bị, hãy sử dụng 120 gam hắc khiên ngưu đầu nhỏ kèm theo 1 thăng cát cánh, sau đó tán bột và hoà trộn để tạo thành viên thuốc cỡ hạt ngô. Uống với nước nóng, mỗi lần khoảng 40 viên và sử dụng hai lần mỗi ngày. Đây là phương pháp được sử dụng để chữa mắt đau do can phong thịnh.
Bài thuốc trị lợi răng loét, chân răng bị sưng đau
Bạn có thể tạo viên thuốc bằng cách trộn bột cát cánh với nhục táo và tạo thành viên to như hạt bồ kết. Sau đó, bọc viên thuốc bằng bông và ngậm chung với nước lá kinh giới. Việc này giúp tăng hiệu quả của trị lợi răng loét, chân răng bị sưng đau.
Bài thuốc điều trị cam ăn làm răng lở thối
Để điều trị cam ăn làm răng lở thối bạn có thể sử dụng 2 bài thuốc sau:
Sử dụng cát cánh và hồi hương với liều lượng bằng nhau, sau đó tán thành bột và đắp lên vùng răng. Phương pháp này cũng được sử dụng để chữa trúng độc, đi tiêu ra phân giống như gan gà.
Khổ cát cánh được tán thành bột. Mỗi ngày, sử dụng 3 lần, mỗi lần dùng 12 gam pha vào rượu và uống. Tiếp tục sử dụng trong vòng 7 ngày, kết hợp với việc ăn gan heo hoặc phổi heo để bồi dưỡng cơ thể, giúp rút ngắn thời gian điều trị và tăng hiệu quả của liệu pháp.
Bài thuốc trị chảy máu mũi
Sử dụng bột cát cánh hòa vào nước và uống. Mỗi ngày, sử dụng 1 muỗng canh bột, chia thành 4 lần uống trong ngày. Đây là một phương pháp đơn giản và dễ thực hiện để tận dụng các tác dụng trị chảy máu mũi.
Bài thuốc trị chứng khóc đêm, khóc không ra hơi gần chết ở trẻ nhỏ
Cát cánh sau khi được đốt và tán nhuyễn thành bột. Mỗi ngày, dùng 12 gram bột này hòa tan vào nước cơm và cho trẻ uống. Đồng thời, cần bổ sung thêm một ít thuốc xạ hương để tăng hiệu quả điều trị. Đây là một phương pháp truyền thống được sử dụng để chăm sóc sức khỏe của trẻ nhỏ khi bị chứng khóc đêm, khóc không ra hơi gần chết ở trẻ nhỏ.
Bài thuốc trị ho hàn đờm lỏng
Để tận dụng các hiệu quả của cát cánh, bạn có thể sử dụng 8 gam cát cánh sắc kết hợp với 4 gam bạc hà, 12 gam hạnh nhân và 12 gam tử tô. Uống liên tục trong 4 ngày để đạt được kết quả tốt nhất.
Bài thuốc chữa ho nhiệt có đờm dẻo đặc
Để tận dụng các tính chất của cát cánh, bạn có thể kết hợp 8 gam cát cánh với 12 gam tang diệp, 12 gam tỳ bà diệp và 4 gam cam thảo để tạo thành một thang thuốc. Mỗi ngày, sắc 1 thang thuốc và uống liên tục trong 2 - 4 ngày để đạt được hiệu quả tốt nhất.
Bài thuốc trị viêm amidan
Để sử dụng cát cánh một cách hiệu quả, bạn có thể kết hợp 8 gam cát cánh với 4 gam sinh cam thảo, 12 gam kim ngân hoa và 12 gam liên kiều. Sau đó, sắc thuốc và uống theo chỉ dẫn.
Bài thuốc chữa phế ung, ngực đầy tức và ho mửa ra mủ đờm
Để tận dụng các tác dụng của cát cánh, bạn có thể sử dụng 4 gam cát cánh kết hợp với 4 gam cam thảo sống, 24 gam đông qua nhân, 12 gam ngân hoa đằng, 40 gam bạch mao căn, 8 gam bối mẫu, 8 gam ngư tinh thảo và 20 gam ý dĩ nhân. Sau đó, sắc và uống theo hướng dẫn.
5Lưu ý khi sử dụng cát cánh
Một số lưu ý khi sử dụng bài thuốc có chứa cát cánh:
- Người bị âm hư ho lâu ngày, ho ra máu.
- Bệnh nhân có bệnh nhưng không thuộc về tạng phế.
- Người không có phong hàn bế tắc ở phế, khí nghịch lên hoặc âm hư hỏa vượng hay ho suyễn, lao tổn.
- Âm hư hỏa nghịch nhưng không có phong hàn ở phế.

Một số lưu ý khi sử dụng bài thuốc có chứa cát cánh
Mặc dù cát cánh mang lại rất nhiều lợi ích đối với sức khỏe con người. Tuy nhiên, để sử dụng cát cánh an toàn và hiệu quả, bạn nên tham khảo ý kiến của bác sĩ hoặc người có chuyên môn trước khi sử dụng.
Xem nguồn
Link bài gốc
Lấy link!https://giadinhmoi.vn/cat-canh-co-tac-dung-gi-cong-dung-va-lieu-dung-cat-canh-d92546.html